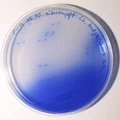

Featured Quizzes
User Quizzes
Create Quiz
Data and Charts
Word Search
Flash Cards
Badges and Games
About JetPunk
Message Board
Dark Mode
Lab Equipment by Picture #1 - Statistics
General Stats
-
This quiz has been taken 82 times
73 since last reset
- The average score is 6 of 10
Answer Stats
| Picture | Answer | % Correct |
|---|---|---|
 | Beaker | 88%
|
 | Funnel | 88%
|
 | Microscope | 88%
|
 | Test tube | 88%
|
 | Syringe | 70%
|
 | Pipette | 63%
|
| Petri dish | 55%
|
 | Spatula | 33%
|
 | Pestle & Mortar | 18%
|
 | Cylinder | 13%
|
No matching quizzes found
Score Distribution
Percent of People with Each Score
Percentile by Number Answered
Your Score History
You have not taken this quiz since the last reset
